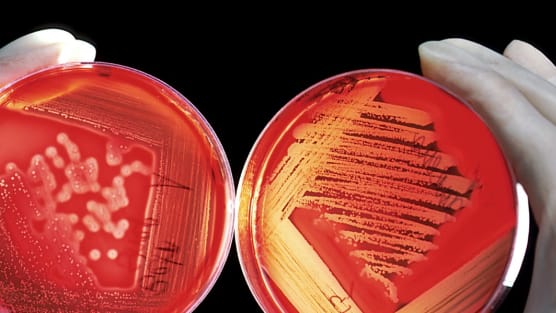
image

Kinderspital Zentralschweiz testet «Martha’s Rule»
Nach einem tragischen Todesfall führt das KidZ ein neues Warn- und Eskalationssystem ein: Es stellt sicher, dass Eltern gehört werden, wenn sie Alarm schlagen.
Loading

Nach einem tragischen Todesfall führt das KidZ ein neues Warn- und Eskalationssystem ein: Es stellt sicher, dass Eltern gehört werden, wenn sie Alarm schlagen.

Angehörige erkennen oft früher als medizinische Profis, wenn sich der Zustand eines Kindes verschlechtert. Eine neue Studie belegt die Bedeutung solcher Bedenken – und plädiert für einen Kulturwandel in der Notfallmedizin.

Laborwerte, Risiken, Therapieeffekte – viele Aufklärungsgespräche scheitern an medizinischen Zahlen. Doch wie erläutert man, was eine Behandlung bringt? Ein Vorschlag.

Ob Spital, Heim oder Praxis: BRITA Wasserspender liefern frisches Trinkwasser auf Knopfdruck – sicher und komfortabel aus der lokalen Leitung. Modernste Filtertechnologie entfernt Mikropartikel, Medikamentenrückstände und über 99% PFAS. BRITA Wasserspender ersetzen Gallonen und Einwegflaschen.

In Deutschland wird ein KI-gestütztes Kamerasystem getestet, das prüft, ob nach der Operation alle chirurgischen Materialien wieder auf dem OP-Tisch sind – und nicht im Patienten.

Kooperationen, weniger Angebote, effizientere Abläufe, Schliessungen, Nullrunden bei den Löhnen: Die öffentlichen Akutspitäler haben viel getan, um die Finanznot zu bekämpfen. Fazit: So geht es trotzdem nicht weiter.

Wir vergleichen das Kispi Zürich mit dem Opernhaus Zürich. Geht das? Durchaus. Denn beide haben dieselbe Aufgabe: zu funktionieren, wo Wirtschaftlichkeit an Grenzen stösst.

Das Bundesgericht greift in die WZW-Ermittlungsverfahren ein: Ein Grundsatzurteil dürfte die gängigen Prozesse umkrempeln.

Palliative Care löst nicht alle Probleme im Gesundheitswesen: … Palliative Care kann jedoch ein Hebel sein.